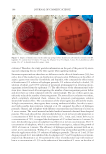
visit page 37

J. Cosmet. Sci., 72, 229–245 (March/April 2021) 229 Selected Alkaloids Used in the Cosmetics Industry ANNA STĘPNIOWSKA, PATRYCJA CIEPLIŃSKA, WERONIKA FAC, and JOANNA GÓRSKA, De partment of Biochemistry and Toxicology, University of Life Sciences in Lublin, Lublin 20-950, Poland (A. S., P.C., W.F., J.G.) Accepted for publication November 18, 2020. Syno p sis Plan ts are a rich source of a wide variety of bioactive compounds that can be used for the preparation of cosmetics. Natural cosmetics with plant components such as vitamins, polyphenols, and alkaloids have become more and more popular. Alkaloids are important secondary metabolites in plants. They are known to possess therapeutic properties. Alkaloids can be used in the production of tonics, creams, lotions, face and hair masks, compresses for skin problems with numerous infl ammations, and discoloration and antiaging products, as well as for reducing the formation of cellulitis. Alkaloids are also used in the production of ampoules for cosmetologists and aesthetic medicine doctors. However, at higher doses, they may exhibit toxic properties. Several studies have been carried out in evaluation of the activity of alkaloids from various plants for their use in cosmetics. This review describes alkaloids (caffeine, capsaicin, berberine, piperine, spilanthol, and anatabine) derived from various plants that are used in cosmetics, as well as their reported activities. INTR O DUCTION Alka loids are a group of secondary plant metabolites containing nitrogen atoms. Ac- cording to Pelletier (1), alkaloid is “a cyclic organic compound containing nitrogen in a negative oxidation state which is of limited distribution among living organisms.” Most of them stimulate physiological processes of living organisms. They are found in plants from the family of poppies (Papav eraceae), leguminous (Fabac eae), nightshade (Solan ceae), papilionaceous (Papil ionaceae), and buttercup (Ranun culaceae), and in fungi (Boletus, Fusarium, and Psilocybe), and club moss (Lycop odiaceae) and horsetails (Equis etaceae) included in the lower plants. Hegnauer (2) defi nes alkaloid plants as those species that contain more than 0.01% in weight of alkaloids. These compounds are most often stored in tubers, roots, seeds, fruits, leaves, fl owers, and the bark. The content of alkaloids is infl uenced by plant development conditions, such as season and microclimate, as well as the degree of maturity of the plant raw material. A single plant may contain several alkaloids with similar or different effects (3). Address all correspondence to Anna Stępniowska at anna.stepniowska@up.lublin.pl.
JOURNAL OF COSMETIC SCIENCE 230 Amon g other properties, alkaloids used in medicine increase blood pressure (caffeine), are used as local anesthetics (morphine), relax smooth muscles (ephedrine and papaverine), have a diuretic effect (theobromine, theophylline, and caffeine), are immunostimulatory (anatabine and piperine), and have anticancer properties (berberine and codeine), as well as antirheumatic properties (capsaicin). However, prolonged use of some alkaloids, e.g., caffeine or codeine, can cause addiction (Table 1). The function of these compounds de- pends on the dose used, e.g., atropine in low doses is used in medicines, whereas in higher ones, it is a strong poison (4). REPO RTED COSMETIC USES OF ALKALOIDS The cosmetics industry uses alkaloids with antimicrobial (berberine and spilanthol) and antioxidant (caffeine, berberine, spilanthol, and capsaicin), for lightening discoloration (berberine), reducing cellulite and wrinkles (caffeine, capsaicin, piperine, and spilanthol), soothing and anti-infl ammatory (anatabine and piperine), and protecting against the harmful effects of ultraviolet ray properties (caffeine) (4). Most often, in the production of cosmetic products, alkaloids are extracted from plants in pure form or their aqueous or alcoholic extracts are used. Because of the aforementioned properties, these compounds can be used in the production of tonics, creams, lotions, face and hair masks, compresses for skin problems with numerous infl ammations, and discoloration and antiaging products, as well as reducing the formation of cellu lite. In addition to traditional external applica- tion on the skin, alkaloids are used in the production of ampoules for cosmetologists and aesthetic medicine doctors. This article summarizes the experimental data relative to the cosmetic effects of some alkaloids. CAFF EINE IN COSMETICS Caff eine (1,3,7-trimethylxanthine) is one of the most popular purine alkaloids of plant origin (Figure 1). Depending on the botanical from which it is obtained, it takes different names. The most popular raw material from which caffeine can be obtained is coffee beans (Coffea L.). Caffeine is also found in tea (Camellia) and is called thein e. Caffeine is also present in cola nuts (Cola acuminate and Cola nitida), in leaves of the Yerba mate (Ilex paraguariensis) and guarana (Paullinia cupana) hence, it is called guara nine. It is also found in small amounts in cocoa. Its content depends on the species of the plant from which the raw material comes, and the method of preparing the drink or preparing the seeds for consumption (5). Purifi ed caffeine comes in the form of a white crystalline pow- der. It has no fragrance and bitter taste. This alkaloid is an active ingredient in some pharmaceutical preparations it is used in cardiological, neurological, and respiratory me- dicinal products (6,7). Caff eine has been used in different kind of cosmetics. Commercially available topical formulations and anti-cellulite cosmetics normally contain 3–7% of this compound (8). Lupi et al. (9) conducted a study on 99 women (20–39 years) with clinically apparent cellulite, who used a solution containing 7% caffeine for 30 d. Women applied 15 mL of the solution to one thigh, while the other was used as control. In 67.7% of women, a re- duction in diameter of the hip was observed. The median circumference reduction in the
Purchased for the exclusive use of nofirst nolast (unknown) From: SCC Media Library & Resource Center (library.scconline.org)